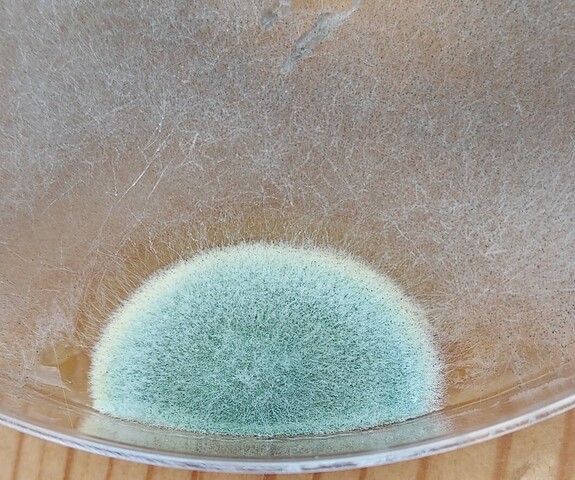

Custom House Studios + Gallery
Westport, Ireland
Multimedia artist Breda Burns represents Custom House Studios + Gallery at SUPERMARKET 2026 with ‘Neurovoices’, an evolving installation exploring neurodivergence and creativity through the lens of her recent ADHD diagnosis.
Layered sound, digital text and transparent sculptural forms combine artists’ voices with recordings from neurodivergent creatives, creating a multisensory, non-linear experience that amplifies overflow and fragmentation rather than masking it.
Based in Westport, Ireland, Burns transforms spaces and materials to examine identity, transparency, vulnerability and strength.